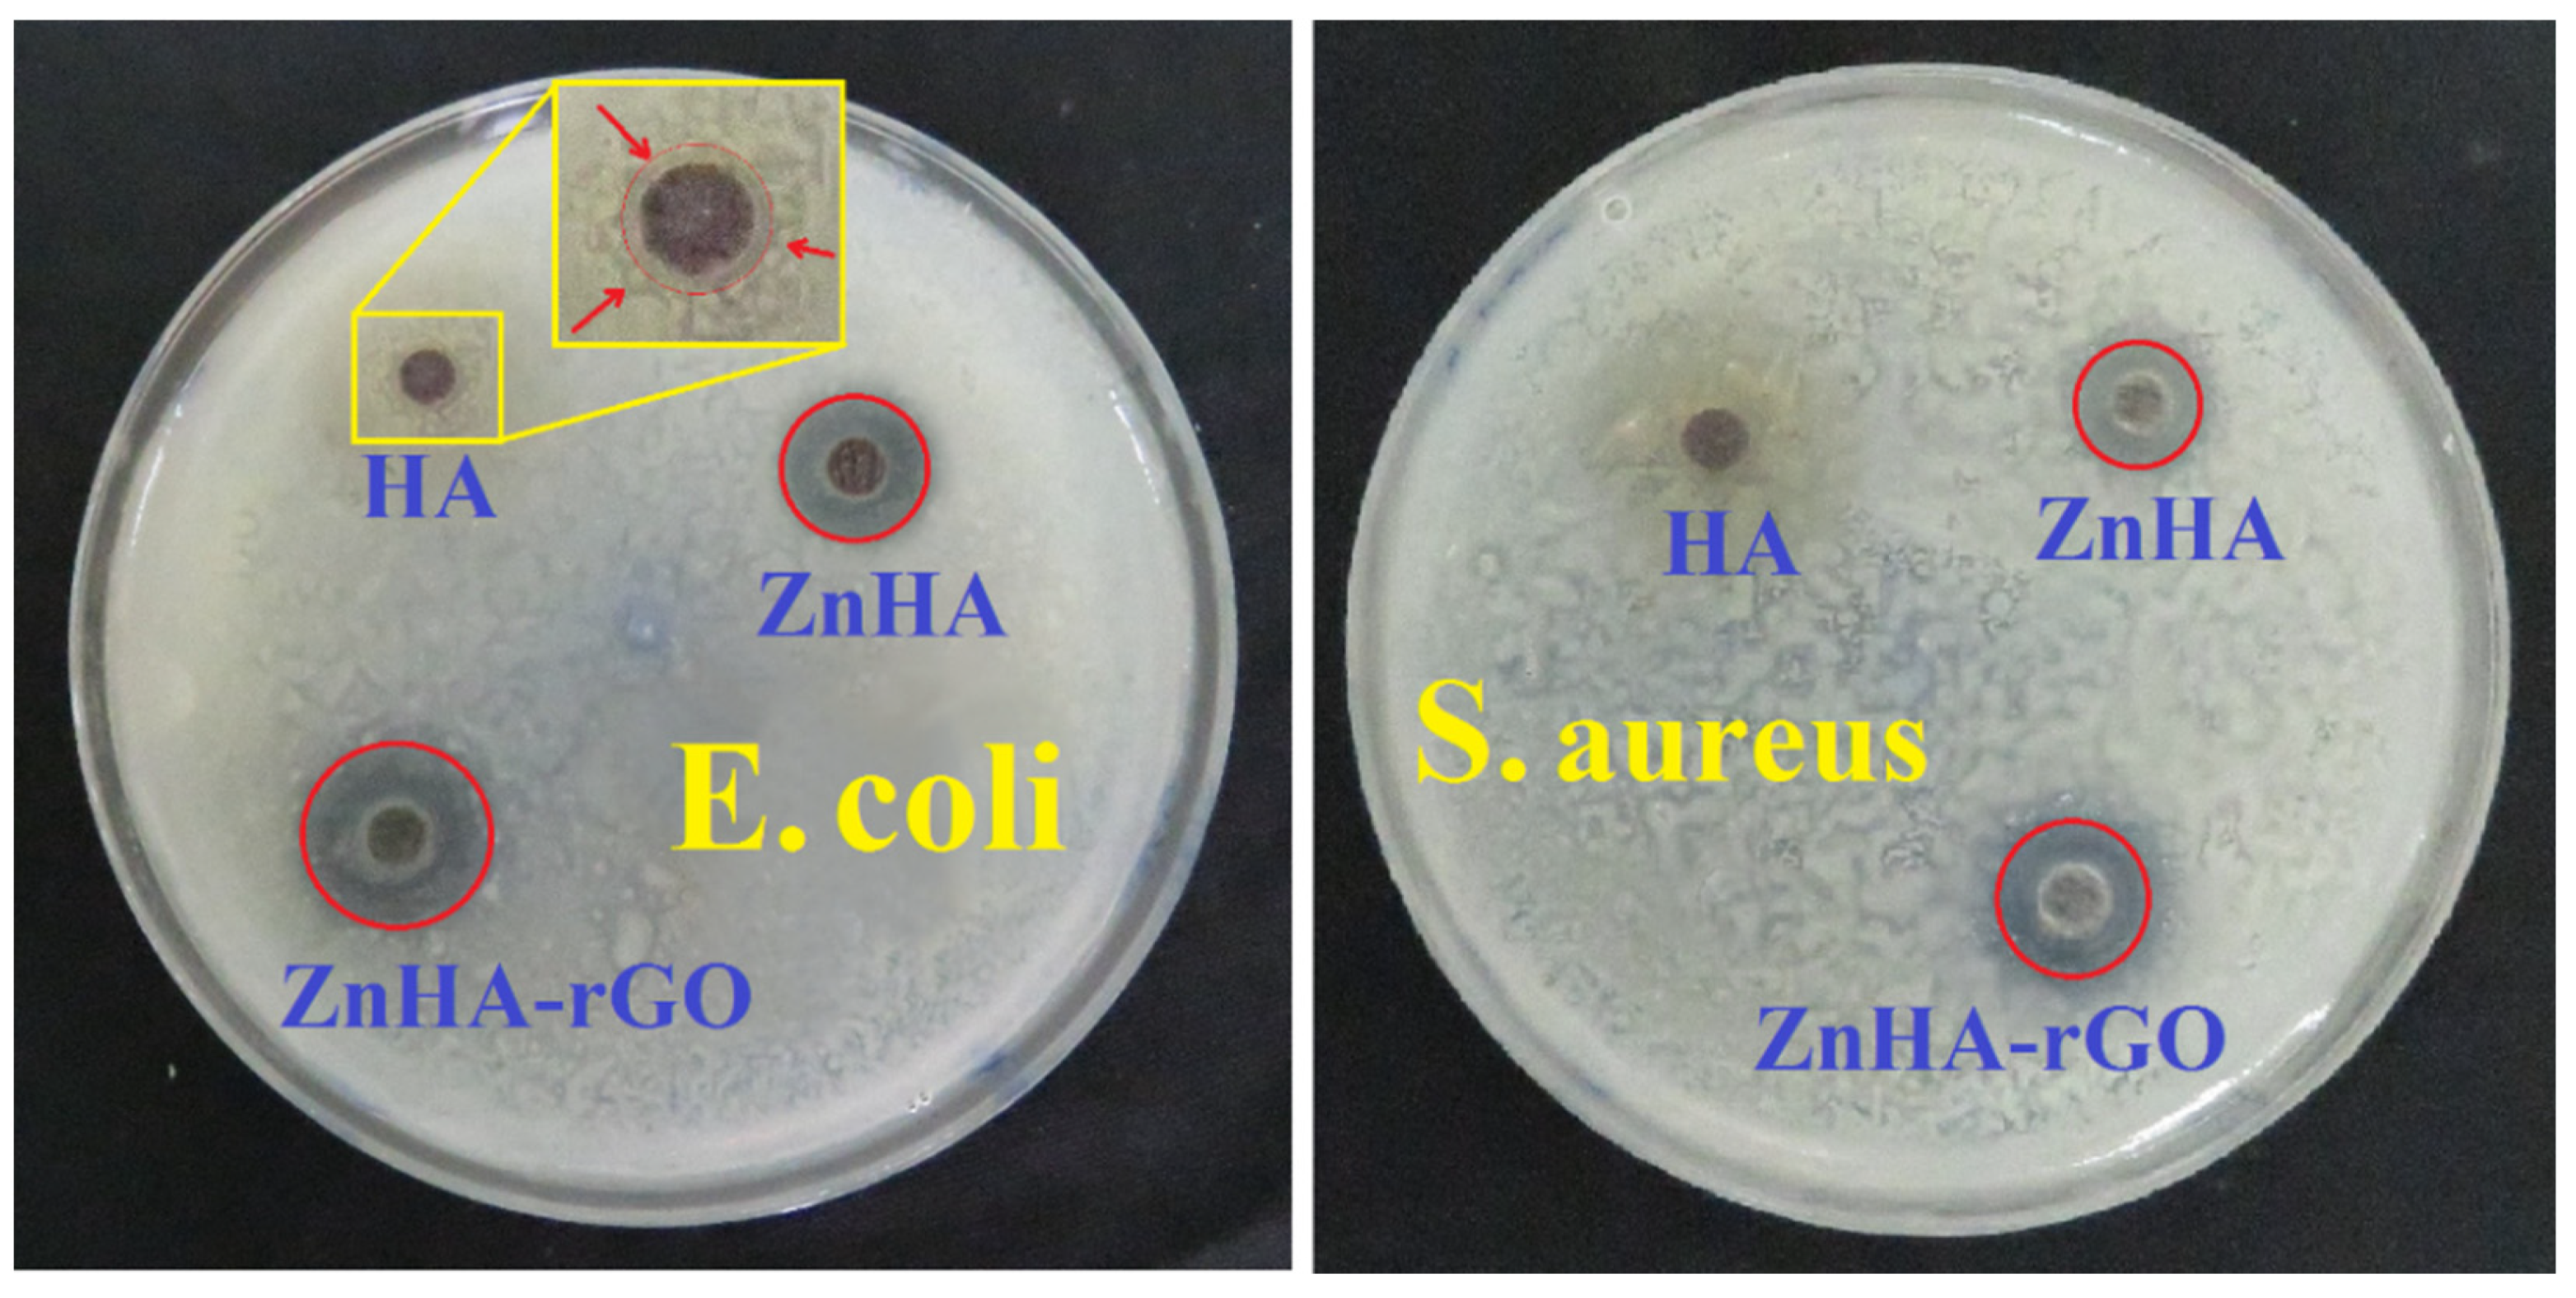
Ijms 22 09564 g007 550

Antibacterial and Cellular Behaviors of Novel Zinc-Doped Hydroxyapatite/Graphene Nanocomposite for Bone Tissue Engineering
Abstract
:1. Introduction
2. Results
2.1. Characterization of Nanoparticles
2.2. In-Vitro Cell Analysis
2.3. Antibacterial Assay
3. Discussion
3.1. Cellular Behavior
3.1.1. Effect of Hydroxyapatite on Cellular Behavior
3.1.2. Effect of Zinc on Cellular Behavior
3.1.3. Effect of rGO on Cellular Behavior
3.1.4. Synergistic Effect in ZnHA-rGO Nanosystem
3.2. Antibacterial Behavior
3.2.1. Effect of Hydroxyapatite on Antibacterial Behavior
3.2.2. Effect of Zinc on Antibacterial Behavior
3.2.3. Effect of rGO on Antibacterial Behavior
4. Materials and Methods
4.1. Material Preparations
4.2. Characterization
4.3. Cellular Behavior
4.3.1. Cell Culture
4.3.2. Cell Viability Assessment
4.3.3. Alkaline Phosphatase Activity
4.4. Antibacterial Activity
4.4.1. Cell Viability Assessment
4.4.2. Disk Diffusion Method
5. Conclusions
Author Contributions
Funding
Institutional Review Board Statement
Informed Consent Statement
Data Availability Statement
Conflicts of Interest
References
- Ribeiro, M.; Monteiro, F.; Ferraz, M.P. Infection of orthopedic implants with emphasis on bacterial adhesion process and techniques used in studying bacterial-material interactions. Biomatter 2012, 2, 176–194. [Google Scholar] [CrossRef] [PubMed] [Green Version]
- Arciola, C.R.; Campoccia, D.; Montanaro, L. Implant infections: Adhesion, biofilm formation and immune evasion. Nat. Rev. Genet. 2018, 16, 397–409. [Google Scholar] [CrossRef] [PubMed]
- Masters, E.A.; Trombetta, R.P.; de Mesy Bentley, K.L.; Boyce, B.F.; Gill, A.L.; Gill, S.R.; Nishitani, K.; Ishikawa, M.; Morita, Y.; Ito, H.; et al. Evolving concepts in bone infection: Redefining “biofilm”, “acute vs. chronic osteomyelitis”, “the immune proteome” and “local antibiotic therapy”. Bone Res. 2019, 15, 1–8. [Google Scholar] [CrossRef] [Green Version]
- Johnson, C.; García, A.J. Scaffold-based anti-infection strategies in bone repair. Ann. Biomed. Eng. 2014, 43, 515–528. [Google Scholar] [CrossRef] [PubMed] [Green Version]
- Vallet-Regí, M.; Lozano, D.; González, B.; Izquierdo-Barba, I. Biomaterials against bone infection. Adv. Healthc. Mater. 2020, 9, 2000310. [Google Scholar] [CrossRef]
- Khalili, V.; Khalil-Allafi, J.; Maleki-Ghaleh, H. Characterisation of HA–Si composite coatings on NiTi for biomedical applications. Surf. Eng. 2013, 30, 212–217. [Google Scholar] [CrossRef]
- Keikhosravani, P.; Maleki-Ghaleh, H.; Khosrowshahi, A.K.; Bodaghi, M.; Dargahi, Z.; Kavanlouei, M.; Khademi-Azandehi, P.; Fallah, A.; Beygi-Khosrowshahi, Y.; Siadati, M.H. Bioactivity and antibacterial behaviors of nanostructured lithium-doped hydroxyapatite for bone scaffold application. Int. J. Mol. Sci. 2021, 22, 9214. [Google Scholar] [CrossRef]
- Khosrowshahi, A.K.; Khoshfetrat, A.B.; Khosrowshahi, Y.B.; Maleki-Ghaleh, H. Cobalt content modulates characteristics and osteogenic properties of cobalt-containing hydroxyapatite in in-vitro milieu. Mater. Today Commun. 2021, 27, 102392. [Google Scholar] [CrossRef]
- Chocholata, P.; Kulda, V.; Babuska, V. Fabrication of scaffolds for bone-tissue regeneration. Materials 2019, 12, 568. [Google Scholar] [CrossRef] [Green Version]
- Maleki-Ghaleh, H.; Aghaie, E.; Nadernezhad, A.; Zargarzadeh, M.; Khakzad, A.; Shakeri, M.S.; Khosrowshahi, Y.B.; Siadati, M.H. Influence of Fe3O4 nanoparticles in hydroxyapatite scaffolds on proliferation of primary human fibroblast cells. J. Mater. Eng. Perform. 2016, 25, 2331–2339. [Google Scholar] [CrossRef]
- Khan, W.S.; Rayan, F.; Dhinsa, B.S.; Marsh, D. An osteoconductive, osteoinductive, and osteogenic tissue-engineered product for trauma and orthopaedic surgery: How far are we? Stem Cells Int. 2011, 2012, 1–7. [Google Scholar] [CrossRef]
- Wang, P.; Zhao, L.; Liu, J.; Weir, M.D.; Zhou, X.; Xu, H.H.K. Bone tissue engineering via nanostructured calcium phosphate biomaterials and stem cells. Bone Res. 2014, 2, 14017. [Google Scholar] [CrossRef]
- Katti, K.S.; Jasuja, H.; Kar, S.; Katti, D.R. Nanostructured biomaterials for in vitro models of bone metastasis cancer. Curr. Opin. Biomed. Eng. 2020, 17, 100254. [Google Scholar] [CrossRef]
- Luo, J.; Mamat, B.; Yue, Z.; Zhang, N.; Xu, X.; Li, Y.; Su, Z.; Ma, C.; Zang, F.; Wang, Y. Multi-metal ions doped hydroxyapatite coatings via electrochemical methods for antibacterial and osteogenesis. Colloid Interface Sci. Commun. 2021, 43, 100435. [Google Scholar] [CrossRef]
- Li, M.; Xiong, P.; Yan, F.; Li, S.; Ren, C.; Yin, Z.; Li, A.; Li, H.; Ji, X.; Zheng, Y.; et al. An overview of graphene-based hydroxyapatite composites for orthopedic applications. Bioact. Mater. 2018, 3, 1–18. [Google Scholar] [CrossRef]
- Pasquet, J.; Chevalier, Y.; Pelletier, J.; Couval, E.; Bouvier, D.; Bolzinger, M.-A. The contribution of zinc ions to the antimicrobial activity of zinc oxide. Colloids Surf. A Physicochem. Eng. Asp. 2014, 457, 263–274. [Google Scholar] [CrossRef]
- Predoi, D.; Iconaru, S.L.; Predoi, M.V.; Motelica-Heino, M.; Guegan, R.; Buton, N. Evaluation of antibacterial activity of zinc-doped hydroxyapatite colloids and dispersion stability using ultrasounds. Nanomaterials 2019, 9, 515. [Google Scholar] [CrossRef] [Green Version]
- Tang, Y.; Rajendran, P.; Veeraraghavan, V.P.; Hussain, S.; Balakrishna, J.P.; Chinnathambi, A.; Alharbi, S.A.; Alahmadi, T.A.; Rengarajan, T.; Mohan, S.K. Osteogenic differentiation and mineralization potential of zinc oxide nanoparticles from Scutellaria baicalensis on human osteoblast-like MG-63 cells. Mater. Sci. Eng. C 2020, 119, 111656. [Google Scholar] [CrossRef]
- Yu, J.; Xu, L.; Li, K.; Xie, N.; Xi, Y.; Wang, Y.; Zheng, X.; Chen, X.; Wang, M.; Ye, X. Zinc-modified calcium silicate coatings promote osteogenic differentiation through TGF-β/Smad pathway and osseointegration in osteopenic rabbits. Sci. Rep. 2017, 7, 1–13. [Google Scholar] [CrossRef] [Green Version]
- Moonga, B.S.; Dempster, D.W. Zinc is a potent inhibitor of osteoclastic bone resorption in vitro. J. Bone Miner. Res. 2009, 10, 453–457. [Google Scholar] [CrossRef]
- Alcantara, E.H.; Lomeda, R.-A.R.; Feldmann, J.; Nixon, G.F.; Beattie, J.H.; Kwun, I.-S. Zinc deprivation inhibits extracellular matrix calcification through decreased synthesis of matrix proteins in osteoblasts. Mol. Nutr. Food Res. 2011, 55, 1552–1560. [Google Scholar] [CrossRef] [PubMed]
- Fu, X.; Li, Y.; Huang, T.; Yu, Z.; Ma, K.; Yang, M.; Liu, Q.; Pan, H.; Wang, H.; Wang, J.; et al. Runx2/Osterix and zinc uptake synergize to orchestrate osteogenic differentiation and citrate containing bone apatite formation. Adv. Sci. 2018, 5, 1700755. [Google Scholar] [CrossRef]
- Chen, C.T.; Shih, Y.R.; Kuo, T.K.; Lee, O.K.; Wei, Y.H. Coordinated changes of mitochondrial biogenesis and antioxidant enzymes during osteogenic differentiation of human mesenchymal stem cells. Stem Cells 2008, 26, 960–968. [Google Scholar] [CrossRef] [PubMed]
- Huang, T.; Liu, R.; Fu, X.; Yao, D.; Yang, M.; Liu, Q.; Lu, W.W.; Wu, C.; Guan, M. Aging reduces an ERRalpha-directed mitochondrial glutaminase expression suppressing glutamine anaplerosis and osteogenic differentiation of mesenchymal stem cells. Stem Cells 2017, 35, 411–424. [Google Scholar] [CrossRef] [Green Version]
- Granchi, D.; Baldini, N.; Ulivieri, F.M.; Caudarella, R. Role of citrate in pathophysiology and medical management of bone diseases. Nutrients 2019, 11, 2576. [Google Scholar] [CrossRef] [Green Version]
- Costello, L.C.; Franklin, R.B.; Liu, Y.; Kennedy, M. Zinc causes a shift toward citrate at equilibrium of the m-aconitase reaction of prostate mitochondria. J. Inorg. Biochem. 2000, 78, 161–165. [Google Scholar] [CrossRef]
- Shareena, T.P.D.; McShan, D.; DasMahapatra, A.K.; Tchounwou, P.B. A review on graphene-based nanomaterials in biomedical applications and risks in environment and health. Nano-Micro Lett. 2018, 10, 1–34. [Google Scholar] [CrossRef]
- Tadyszak, K.; Wychowaniec, J.K.; Litowczenko, J. Biomedical applications of graphene-based structures. Nanomaterials 2018, 8, 944. [Google Scholar] [CrossRef] [Green Version]
- Kang, M.S.; Jeong, S.J.; Lee, S.H.; Kim, B.; Hong, S.W.; Lee, J.H.; Han, D.-W. Reduced graphene oxide coating enhances osteogenic differentiation of human mesenchymal stem cells on Ti surfaces. Biomater. Res. 2021, 25, 1–9. [Google Scholar] [CrossRef] [PubMed]
- Qiu, J.; Geng, H.; Wang, D.; Qian, S.; Zhu, H.; Qiao, Y.; Qian, W.; Liu, X. Layer-number dependent antibacterial and osteogenic behaviors of graphene oxide electrophoretic deposited on titanium. ACS Appl. Mater. Interfaces 2017, 9, 12253–12263. [Google Scholar] [CrossRef]
- Liu, S.; Zeng, T.H.; Hofmann, M.; Burcombe, E.; Wei, J.; Jiang, R.; Kong, J.; Chen, Y. Antibacterial activity of graphite, graphite oxide, graphene oxide, and reduced graphene oxide: Membrane and oxidative stress. ACS Nano 2011, 5, 6971–6980. [Google Scholar] [CrossRef]
- Lee, J.H.; Shin, Y.C.; Jin, O.S.; Kang, S.H.; Hwang, Y.-S.; Park, J.-C.; Hong, S.W.; Han, D.-W. Reduced graphene oxide-coated hydroxyapatite composites stimulate spontaneous osteogenic differentiation of human mesenchymal stem cells. Nanoscale 2015, 7, 11642–11651. [Google Scholar] [CrossRef]
- Hermenean, A.; Dinescu, S.; Ionita, M.; Costache, M. The impact of graphene oxide on bone regeneration therapies. Adv. Technol. 2016. [Google Scholar] [CrossRef] [Green Version]
- Maleki-Ghaleh, H.; Siadati, M.H.; Fallah, A.; Zarrabi, A.; Afghah, F.; Koc, B.; Abdolahinia, E.D.; Omidi, Y.; Barar, J.; Akbari-Fakhrabadi, A.; et al. Effect of zinc-doped hydroxyapatite/graphene nanocomposite on the physicochemical properties and osteogenesis differentiation of 3D-printed polycaprolactone scaffolds for bone tissue engineering. Chem. Eng. J. 2021, 426, 131321. [Google Scholar] [CrossRef]
- Maleki-Ghaleh, H.; Khalil-Allafi, J. Effect of hydroxyapatite-titanium-MWCNTs composite coating fabricated by electrophoretic deposition on corrosion and cellular behavior of NiTi alloy. Mater. Corros. 2019, 70, 2128–2138. [Google Scholar] [CrossRef]
- Maleki-Ghaleh, H.; Khalili, V.; Khalil-Allafi, J.; Javidi, M.M. Hydroxyapatite coating on NiTi shape memory alloy by electrophoretic deposition process. Surf. Coat. Technol. 2012, 208, 57–63. [Google Scholar] [CrossRef]
- Maleki-Ghaleh, H.; Khalil-Allafi, J.; Horandghadim, N.; Keikhosravani, P.; Hosseini, M.G. Structural characterization, mechanical, and electrochemical studies of hydroxyapatite-titanium composite coating fabricated using electrophoretic deposition and reaction bonding process. J. Biomed. Mater. Res. Part B Appl. Biomaterials. 2020, 108, 2119–2130. [Google Scholar] [CrossRef]
- Khalili, V.; Khalil-Allafi, J.; Maleki-Ghaleh, H.; Paulsen, A.; Frenzel, J.; Eggeler, G. The influence of Si as reactive bonding agent in the electrophoretic coatings of HA-Si-MWCNTs on NiTi alloys. J. Mater. Eng. Perform. 2015, 25, 390–400. [Google Scholar] [CrossRef]
- Saleem, H.; Haneef, M.; Abbasi, H.Y. Synthesis route of reduced graphene oxide via thermal reduction of chemically exfoliated graphene oxide. Mater. Chem. Phys. 2018, 204, 1–7. [Google Scholar] [CrossRef]
- Guerra-López, J.R.; Echeverría, G.A.; Güida, J.A.; Viña, R.; Punte, G. Synthetic hydroxyapatites doped with Zn (II) studied by X-ray diffraction, infrared, Raman and thermal analysis. J. Phys. Chem. Solids 2015, 1, 57–65. [Google Scholar] [CrossRef]
- Yuan, Q.; Wu, J.; Qin, C.; Xu, A.; Zhang, Z.; Lin, Y.; Chen, Z.; Lin, S.; Yuan, Z.; Ren, X.; et al. One-pot synthesis and characterization of Zn-doped hydroxyapatite nanocomposites. Mater. Chem. Phys. 2017, 199, 122–130. [Google Scholar] [CrossRef]
- Jastrzębski, W.; Sitarz, M.; Rokita, M.; Bułat, K. Infrared spectroscopy of different phosphates structures. Spectrochim. Acta Mol. Biomol. Spectrosc. 2011, 79, 722–727. [Google Scholar] [CrossRef]
- Alam, M.K.; Rahman, M.M.; Elzwawy, A.; Torati, S.R.; Islam, M.S.; Todo, M.; Asiri, A.M.; Kim, D.; Kim, C. Highly sensitive and selective detection of Bis-phenol A based on hydroxyapatite decorated reduced graphene oxide nanocomposites. Electrochim. Acta. 2017, 241, 353–361. [Google Scholar] [CrossRef]
- Maleki-Ghaleh, H.; Khalil-Allafi, J.; Keikhosravani, P.; Etminanfar, M.R.; Behnamian, Y. Effect of nano-zirconia on microstructure and biological behavior of hydroxyapatite-based bone scaffolds. J. Mater. Eng. Perform. 2020, 29, 4412–4420. [Google Scholar] [CrossRef]
- Sharma, U.; Pal, D.; Prasad, R. Alkaline phosphatase: An overview. Indian J. Clin. Biochem. 2014, 29, 269–278. [Google Scholar] [CrossRef] [Green Version]
- Blair, H.C.; Larrouture, Q.C.; Li, Y.; Lin, H.; Beer-Stoltz, D.; Liu, L.; Tuan, R.S.; Robinson, L.J.; Schlesinger, P.H.; Nelson, D.J. Osteoblast differentiation and bone matrix formation in vivo and in vitro. Tissue Eng. Rev. 2017, 23, 268–280. [Google Scholar] [CrossRef] [PubMed] [Green Version]
- Xu, D.; Wan, Y.; Li, Z.; Wang, C.; Zou, Q.; Du, C.; Wang, Y. Tailorable hierarchical structures of biomimetic hydroxyapatite micro/nano particles promoting endocytosis and osteogenic differentiation of stem cells. Biomater. Sci. 2020, 8, 3286–3300. [Google Scholar] [CrossRef] [PubMed]
- Yu, X.; Zhang, Q.; Zhao, Y.; Schwarz, B.J.; Stallone, J.N.; Heaps, C.L.; Han, G. Activation of G protein-coupled estrogen receptor 1 induces coronary artery relaxation via Epac/Rap1-mediated inhibition of RhoA/Rho kinase pathway in parallel with PKA. PLoS ONE 2017, 12, e0173085. [Google Scholar] [CrossRef] [Green Version]
- Heiser, J.H.; Schuwald, A.M.; Sillani, G.; Ye, L.; Müller, W.E.; Leuner, K. TRPC 6 channel-mediated neurite outgrowth in PC 12 cells and hippocampal neurons involves activation of RAS/MEK/ERK, PI 3K, and CAMKIV signaling. J. Neurochem. 2013, 127, 303–313. [Google Scholar] [CrossRef]
- Amarasekara, D.; Kim, S.; Rho, J. Regulation of osteoblast differentiation by cytokine networks. Int. J. Mol. Sci. 2021, 22, 2851. [Google Scholar] [CrossRef]
- O’Connor, J.P.; Kanjilal, D.; Teitelbaum, M.; Lin, S.S.; Cottrell, J.A. Zinc as a therapeutic agent in bone regeneration. Materials 2020, 13, 2211. [Google Scholar] [CrossRef]
- Wu, M.; Chen, G.; Li, Y.P. TGF-β and BMP signaling in osteoblast, skeletal development, and bone formation, homeostasis and disease. Bone Res. 2016, 4, 1–21. [Google Scholar] [CrossRef]
- Mitsui, Y.; Hirata, H.; Arichi, N.; Hiraki, M.; Yasumoto, H.; Chang, I.; Fukuhara, S.; Yamamura, S.; Shahryari, V.; Deng, G.; et al. Inactivation of bone morphogenetic protein 2 may predict clinical outcome and poor overall survival for renal cell carcinoma through epigenetic pathways. Oncotarget 2015, 6, 9577–9591. [Google Scholar] [CrossRef] [Green Version]
- Park, K.H.; Choi, Y.; Yoon, D.S.; Lee, K.M.; Kim, D.; Lee, J.W. Zinc promotes osteoblast differentiation in human mesenchymal stem cells via activation of the cAMP-PKA-CREB signaling pathway. Stem Cells Dev. 2018, 27, 1125–1135. [Google Scholar] [CrossRef]
- Peng, S.; Feng, P.; Wu, P.; Huang, W.; Yang, Y.; Guo, W.; Gao, C.; Shuai, C. Graphene oxide as an interface phase between polyetheretherketone and hydroxyapatite for tissue engineering scaffolds. Sci. Rep. 2017, 7, srep46604. [Google Scholar] [CrossRef]
- Han, S.; Kim, J.; Lee, G.; Kim, D. Mechanical properties of materials for stem cell differentiation. Adv. Biosyst. 2020, 4, e2000247. [Google Scholar] [CrossRef]
- Stutchbury, B.; Atherton, P.; Tsang, R.; Wang, D.-Y.; Ballestrem, C. Distinct focal adhesion protein modules control different aspects of mechanotransduction. J. Cell Sci. 2017, 130, 1612–1624. [Google Scholar] [CrossRef] [Green Version]
- Footer, M.J.; Kerssemakers, J.W.J.; Theriot, J.; Dogterom, M. Direct measurement of force generation by actin filament polymerization using an optical trap. Proc. Natl. Acad. Sci. USA 2007, 104, 2181–2186. [Google Scholar] [CrossRef] [Green Version]
- Park, J.H.; Shin, J.E.; Park, H.W. The role of hippo pathway in cancer stem cell biology. Mol. Cells 2018, 41, 83–92. [Google Scholar] [CrossRef] [PubMed]
- Yang, C.-M.; Ji, S.; Li, Y.; Fu, L.-Y.; Jiang, T.; Meng, F.-D. β-Catenin promotes cell proliferation, migration, and invasion but induces apoptosis in renal cell carcinoma. Oncotargets Ther. 2017, 10, 711–724. [Google Scholar] [CrossRef] [PubMed] [Green Version]
- Halim, A.; Liu, L.; Ariyanti, A.D.; Ju, Y.; Luo, Q.; Song, G. Low-dose suspended graphene oxide nanosheets induce antioxidant response and osteogenic differentiation of bone marrow-derived mesenchymal stem cells via JNK-dependent FoxO1 activation. J. Mater. Chem. B 2019, 7, 5998–6009. [Google Scholar] [CrossRef]
- Li, X.; Guo, C.; Li, Y.; Li, L.; Wang, Y.; Zhang, Y.; Li, Y.; Chen, Y.; Liu, W.; Gao, L. Ketamine administered pregnant rats impair learning and memory in offspring via the CREB pathway. Oncotarget 2017, 8, 32433–32449. [Google Scholar] [CrossRef] [Green Version]
- Ragab, H.S.; Ibrahim, F.A.; Abdallah, F.; Al-Ghamdi, A.A.; El-Tantawy, F.; Yakuphanoglu, F. Synthesis and in vitro antibacterial properties of hydroxyapatite nanoparticles. IOSR J. Pharm. Biol. Sci. 2014, 9, 77–85. [Google Scholar] [CrossRef]
- Sadat-Shojai, M.; Khorasani, M.T.; Dinpanah-Khoshdargi, E.; Jamshidi, A. Synthesis methods for nanosized hydroxyapatite with diverse structures. Acta Biomater. 2013, 9, 7591–7621. [Google Scholar] [CrossRef]
- Wang, M.; Li, M.; Wang, Y.; Shao, Y.; Zhu, Y.; Yang, S. Efficient antibacterial activity of hydroxyapatite through ROS generation motivated by trace Mn(iii) coupled H vacancies. J. Mater. Chem. B 2021, 9, 3401–3411. [Google Scholar] [CrossRef] [PubMed]
- Dimapilis, E.A.S.; Hsu, C.-S.; Mendoza, R.M.O.; Lu, M.-C. Zinc oxide nanoparticles for water disinfection. Sustain. Environ. Res. 2017, 28, 47–56. [Google Scholar] [CrossRef]
- Rutherford, D.; Jíra, J.; Kolářová, K.; Matolínová, I.; Mičová, J.; Remeš, Z.; Rezek, B. Growth inhibition of gram-positive and gram-negative bacteria by zinc oxide hedgehog particles. Int. J. Nanomed. 2021, 16, 3541–3554. [Google Scholar] [CrossRef]
- Sinha, R.; Karan, R.; Sinha, A.; Khare, S. Interaction and nanotoxic effect of ZnO and Ag nanoparticles on mesophilic and halophilic bacterial cells. Bioresour. Technol. 2011, 102, 1516–1520. [Google Scholar] [CrossRef] [PubMed]
- Kadiyala, U.; Turali-Emre, E.S.; Bahng, J.H.; Kotov, N.A.; Vanepps, J.S. Unexpected insights into antibacterial activity of zinc oxide nanoparticles against methicillin resistant Staphylococcus aureus (MRSA). Nanoscale 2018, 10, 4927–4939. [Google Scholar] [CrossRef] [PubMed]
- Yusof, H.M.; Mohamad, R.; Zaidan, U.H.; Rahman, N.A.A. Microbial synthesis of zinc oxide nanoparticles and their potential application as an antimicrobial agent and a feed supplement in animal industry: A review. J. Anim. Sci. Biotechnol. 2019, 10, 1–22. [Google Scholar] [CrossRef]
- Pulingam, T.; Thong, K.L.; Ali, E.; Appaturi, J.N.; Dinshaw, I.J.; Ong, Z.Y.; Leo, B.F. Graphene oxide exhibits differential mechanistic action towards Gram-positive and Gram-negative bacteria. Colloids Surf. Biointerfaces 2019, 181, 6–15. [Google Scholar] [CrossRef] [PubMed]
- Xia, M.-Y.; Xie, Y.; Yu, C.-H.; Chen, G.-Y.; Li, Y.-H.; Zhang, T.; Peng, Q. Graphene-based nanomaterials: The promising active agents for antibiotics-independent antibacterial applications. J. Control. Release 2019, 307, 16–31. [Google Scholar] [CrossRef] [PubMed]

Publisher’s Note: MDPI stays neutral with regard to jurisdictional claims in published maps and institutional affiliations. |
© 2021 by the authors. Licensee MDPI, Basel, Switzerland. This article is an open access article distributed under the terms and conditions of the Creative Commons Attribution (CC BY) license (https://creativecommons.org/licenses/by/4.0/).
Share and Cite
Maleki-Ghaleh, H.; Siadati, M.H.; Fallah, A.; Koc, B.; Kavanlouei, M.; Khademi-Azandehi, P.; Moradpur-Tari, E.; Omidi, Y.; Barar, J.; Beygi-Khosrowshahi, Y.; et al. Antibacterial and Cellular Behaviors of Novel Zinc-Doped Hydroxyapatite/Graphene Nanocomposite for Bone Tissue Engineering. Int. J. Mol. Sci. 2021, 22, 9564. https://doi.org/10.3390/ijms22179564
Maleki-Ghaleh H, Siadati MH, Fallah A, Koc B, Kavanlouei M, Khademi-Azandehi P, Moradpur-Tari E, Omidi Y, Barar J, Beygi-Khosrowshahi Y, et al. Antibacterial and Cellular Behaviors of Novel Zinc-Doped Hydroxyapatite/Graphene Nanocomposite for Bone Tissue Engineering. International Journal of Molecular Sciences. 2021; 22(17):9564. https://doi.org/10.3390/ijms22179564
Chicago/Turabian StyleMaleki-Ghaleh, H., M. H. Siadati, A. Fallah, B. Koc, M. Kavanlouei, P. Khademi-Azandehi, E. Moradpur-Tari, Y. Omidi, J. Barar, Y. Beygi-Khosrowshahi, and et al. 2021. "Antibacterial and Cellular Behaviors of Novel Zinc-Doped Hydroxyapatite/Graphene Nanocomposite for Bone Tissue Engineering" International Journal of Molecular Sciences 22, no. 17: 9564. https://doi.org/10.3390/ijms22179564
APA StyleMaleki-Ghaleh, H., Siadati, M. H., Fallah, A., Koc, B., Kavanlouei, M., Khademi-Azandehi, P., Moradpur-Tari, E., Omidi, Y., Barar, J., Beygi-Khosrowshahi, Y., Kumar, A. P., & Adibkia, K. (2021). Antibacterial and Cellular Behaviors of Novel Zinc-Doped Hydroxyapatite/Graphene Nanocomposite for Bone Tissue Engineering. International Journal of Molecular Sciences, 22(17), 9564. https://doi.org/10.3390/ijms22179564

